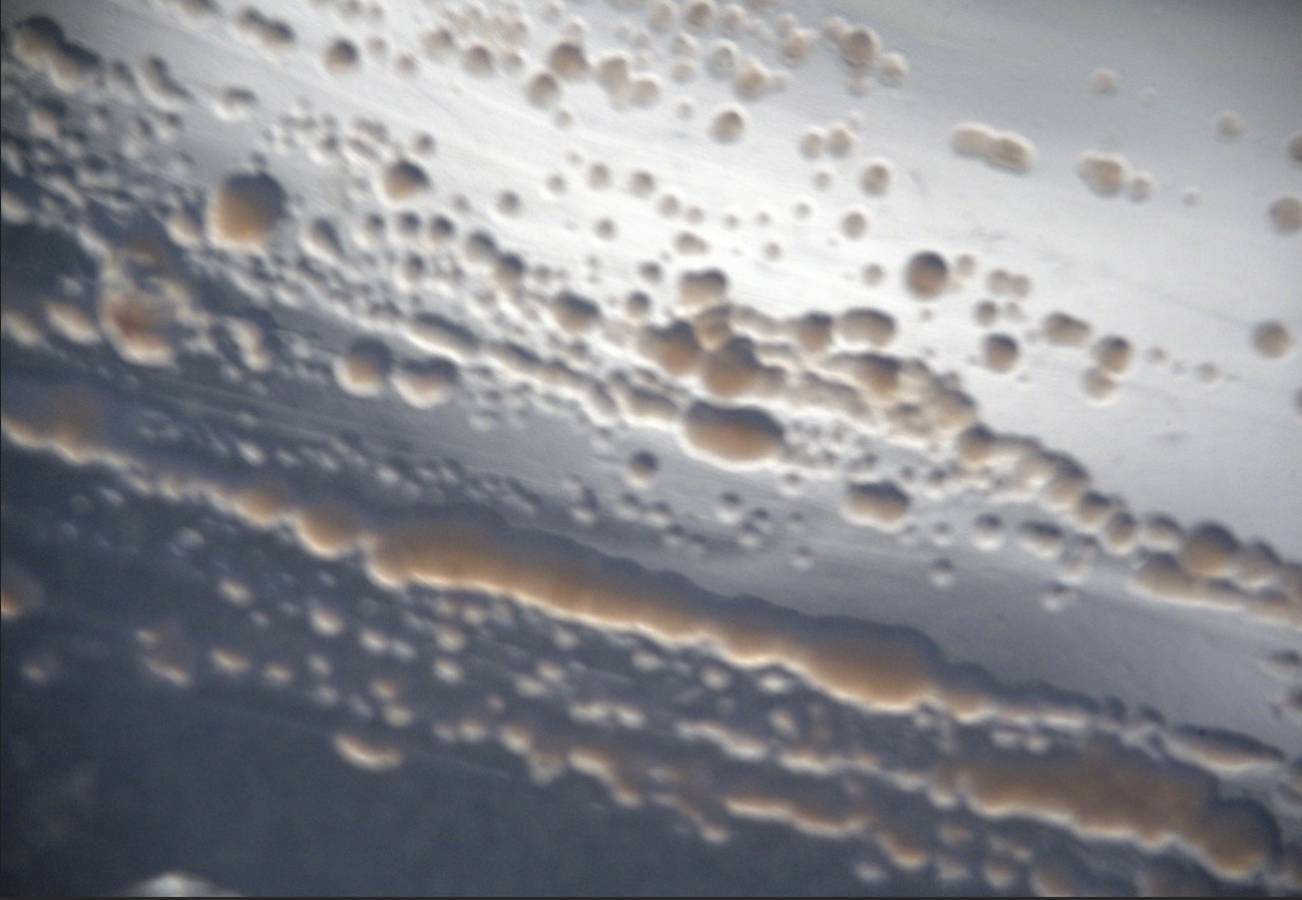

Microorganismos del desierto de Atacama: Posible clave para la detección de vida en otros planetas
- Por Megatiempo
Un estudio, liderado por investigadoras del Centro de Astrofísica y Tecnologías Afines (CATA), propone que los gases producidos por microorganismos del desierto de Atacama podrían ser claves para la detección de vida en exoplanetas similares a la Tierra primitiva.
Este se centró en Roseovarius sp., una bacteria que está aislada en el Salar de Llamara, un lugar que funciona como reflejo de las condiciones que pudieron existir en la Tierra hace millones de años.
Estudio de bacteria del desierto de Atacama
Según la investigadora Valeska Molina, se analizaron los gases producidos por la bacteria Roseovarius, como el monóxido de carbono (CO) y dióxido de carbono (CO?), junto a sus firmas espectrales por medio de espectroscopía Raman e infrarroja.
Las señales obtenidas se compararon después "con modelos de atmósferas planetarias análogas a la Tierra primitiva". Estas simulaciones podrían demostrar si las biofirmas de exoplanetas pueden detectarse a través de telescopios como el James Webb Space Telescope (JWST) o futuros instrumentos, como reseña CATA.
Las investigadoras esperan aplicar este estudio a otros microorganismos extremófilos para "mejorar estos modelos atmosféricos incorporando la relación estrella-planeta".



En este sentido, la científica Cristina Dorador destaca la importancia de proteger ambientes análogos a la Tierra primitiva como los del desierto de Atacama, los cuales "están cada vez más amenazados".
Busca aquí el pronóstico de tu localidadLeer más de